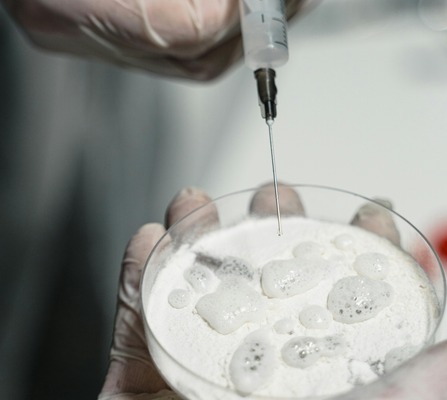

Our advanced food & drug testing lab ensures ultra-precise detection of impurities and adulterants using globally certified methods and advanced technology.
- Equipped with world-class instruments: ICP-MS, AES (Agilent - USA), LC-MSMS, GC-MSMS, QToF (Waters - USA)
- Detects heavy metals, pesticide residues, contaminants, pathogens & adulterants at ultra-trace levels (ppb/ppt)
- Tests conducted as per international standards: FSSAI, CODEX, USFDA, WHO, AOAC & Pharmacopoeial guidelines
- Ideal for food safety, pharma compliance, and quality control
- Ensures safe, accurate, and reliable results every time